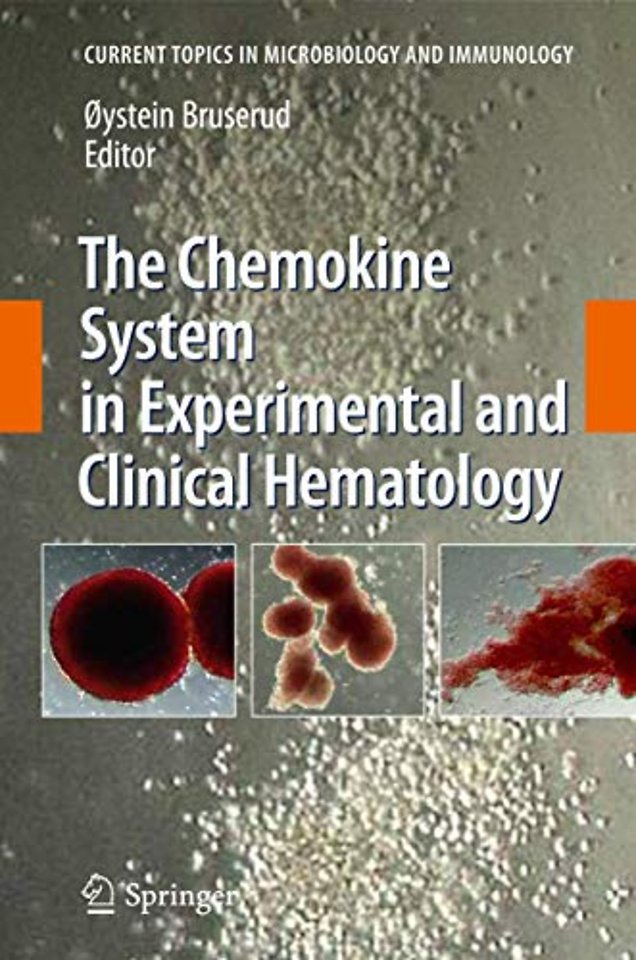
The Chemokine System in Experimental and Clinical Hematology

The Chemokine System in Experimental and Clinical Hematology
Samenvatting
The aim of the issue is to describe and explain the importance of the chemokine system in hematology. The chemokine system is probably important for many aspects of normal as well as malignant hematopoiesis. A major focus is the development and treatment of hematologic malignancies, including the immunobiology of stem cell transplantation. The present reviews illustrate that chemokines can be involved in leukemogenesis. The chemokine system is also important both for the crosstalk between malignant cells and their neighbouring nonmalignant stromal cells (including endothelial cells) as well as for immunoregulation in patients treated with allogeneic stem cell transplantation. Thus, chemokines are important both for the pathogenesis and treatment of hematological diseases.
Specificaties
Inhoudsopgave
Expermimental Hematology.- Chemokine decoy receptors – structure-function and biological properties.- Role of chemokines in the biology of natural killer cells.- Chemokines in angiogenesis.- Immunobiology of Allogenetic Stem Cell Transplantation.-
Genetic polymorphisms in the cytokine and chemokine system – their possible importance in allogeneic stem cell transplantation.- The chemokine system - a possible therapeutic target in graft versus host disease.- Homing in on acute graft versus host disease: Tissue-specific T regulatory and Th17 cells.- Clinical Hematology.- The chemokine network in acute myelogenous leukemia: molecular mechanisms involved in leukemogenesis and therapeutic implications.- CXCR4 in clinical hematology.- Immunobiology of heparin-induced thrombocytopenia.- Subject index.